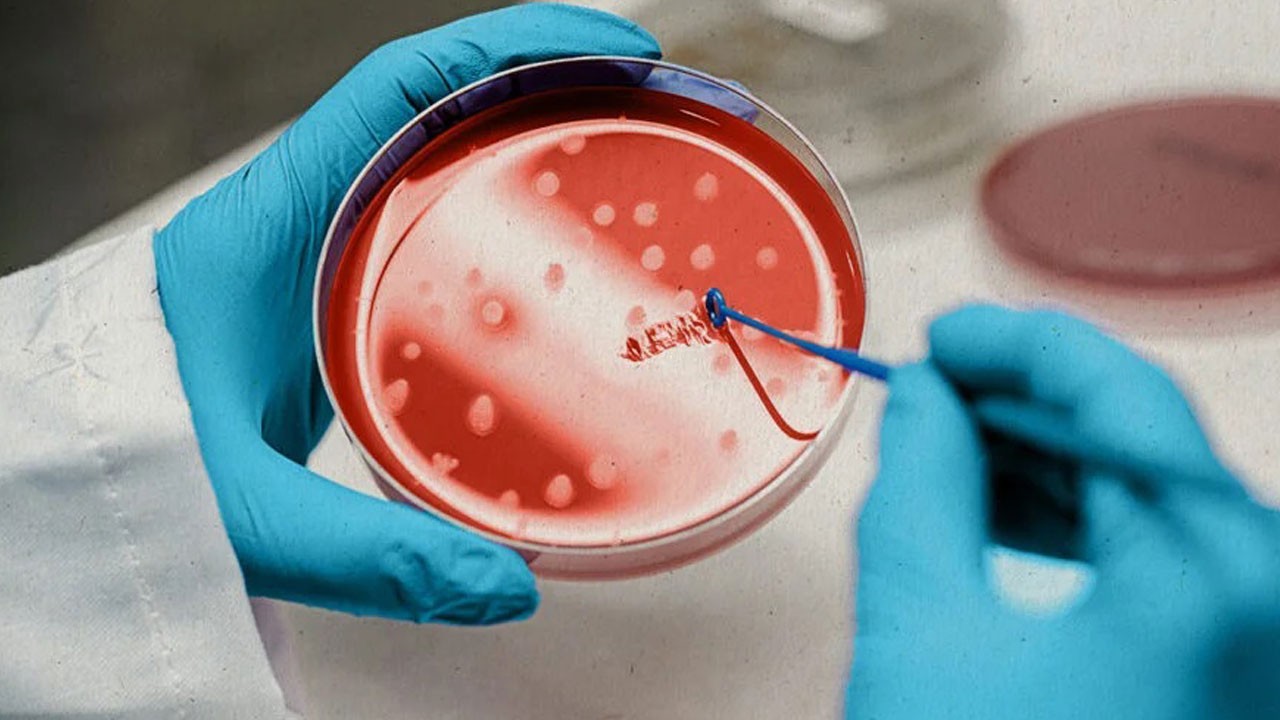
Kök Hücre Tedavisi Nedir? Hangi Hastalıklarda Kullanılır?

Okullarda görünmez tehlike! Çocuklar intihara sürükleniyor

Yeni eğitim-öğretim yılıyla birlikte akran zorbalığı yeniden gündeme geldi. Uzman Klinik Psikolog Kerime Begüm Özkaya, fark edilmeyen zorbalığın çocuklarda ağır psikolojik sorunlara yol açabileceğini belirtti.
Okul koridorlarında sessizce başlayan bir zorbalık, çocuğun hayatını karartacak noktaya kadar uzanabiliyor. Bir çocuğun bir veya birden fazla akranı tarafından tekrar tekrar ve kasıtlı biçimde kötü muameleye maruz kalması olarak tanımlanan akran zorbalığı, güç kazanma isteği ve ailevi sorunlar gibi nedenlerle hem zorbalığa maruz kalabiliyor hem de zorbalığı uygulayabiliyor. Sadece bir defalık tartışma veya kavga olarak değerlendirilmemesi gereken bu durum, fiziksel, psikolojik, sosyal ve duygusal zorbalık olmak üzere farklı şekillerde ortaya çıkabiliyor. Zorbalığa maruz kalan çocukların yaşadığı psikolojik etkiler, kısa vadede okul başarısının düşmesinden gelecek yaşantısına kadar uzanırken, uzun vadede çok daha ağır sonuçlara neden olabiliyor. Konuya ilişkin açıklamalarda bulunan Medicana Sivas Hastanesinde görevli Uzman Klinik Psikolog Kerime Begüm Özkaya, okullarda öğretmenlere, evlerde ise anne babalara büyük sorumluluk düştüğünü belirterek, zorbalığın fark edilmezse çocukların kendilerine zarar verme, intihar etme, arkadaşlarına kötü davranma gibi ciddi sorunlarla karşı karşıya kalabileceğini vurguladı.
Akran zorbalığının sebebi ne?
Akran zorbalığının her yaşta görülebileceğini belirten Kerime Begüm Özkaya, "Akran zorbalığı, bir çocuğun bir veya daha fazla akranı tarafından tekrar tekrar ve kasıtlı biçimde kötü muameleye maruz kaldığı bir istismar türüdür. Genel olarak fiziksel, psikolojik, ruhsal ve duygusal zorbalık olarak bilinmektedir. Sadece bir kez yapılan tartışma ya da kavga değil, sistemli ve süreklilik gösteren olumsuz davranışlardır. Her yaş grubunda görülür ama 7-15 yaş arasındaki çocuklarda sıklıkla karşımıza çıkar. Nedenleri arasında çocuklar arası kendini güçlü gösterme çabası, ailevi sorunlar, öfke kontrolsüzlüğü, çocuğun kendi öfkesini kontrol edemeyip etrafındaki çocuklara zarar vermesi yer alır. Çocuklar sosyal medyada kendilerine bir karakter belirleyebilir ve belirledikleri karakteri yansıtabilmek adına onun kötü hareket ve davranışlarını tekrar edebilir. Medyada şiddetin normalleştirilmesi, cinsiyet kalıpları, arkadaş gruplarında güç, popülerlik ve baskın olma isteği de nedenleri arasında bulunmaktadır" dedi.
"Sınır koymayı öğretmelilerdir"
Özkaya, akran zorbalığı konusunda bilinçli olunması gerektiğine dikkat çekerek, "Zorbalığa maruz kalan çocuklarda kaygı, depresyon, özgüven kaybı, okula gitmek istememe, akademik başarının düşmesi, sosyal çekilme ve yalnızlık görülür. Uyku ve iştah bozuklukları sıklıkla karşımıza çıkar. Okulla ilgili konular sorulduğunda öfke, nefret ya da sessiz kalma gibi davranışlarda bulunabilir. Ani ses ve olaylarda kendini korumaya çalışmak, savunma pozisyonu almak, aşırı içine kapanma veya aşırı öfke durumları gözlemlenebilir. Okullarda öğretmenlere, evlerde ise anne babalara büyük sorumluluk düşmektedir. En temel görev, öğretmenlerin ve ailelerin bilinçli bir şekilde bu durumlara müdahale etmesidir. Okullarda verilen eğitimlerde öğretmenler, ebeveynler ve öğrenciler bu konuda bilinçlendirilmeli, çözüm için iletişim kurulabilecek kurumlar anlatılmalıdır. Ders aralarında öğrenciler gözlemlenmeli, muhtemel bir durumda öğretmenler tarafından müdahale edilmelidir. Aileler, çocuklarıyla akran zorbalığı hakkında konuşurken hassas ve destekleyici bir yaklaşım benimsemeli, çocuklara ‘hayır’ demeyi ve sınır koymayı öğretmelidir. Açık iletişim kurmaları teşvik edilmeli, zorbalıkla karşılaştıklarında aileleriyle rahatça konuşabilecekleri bir diyalog ortamı oluşturulmalıdır. Çocukların ihtiyaç duydukları duygusal destek sağlanmalı ve ‘Biz senin yanındayız’ mesajı verilmelidir" diye konuştu.
“İlerleyen yaşlar ciddi sorunlar yaşanabilir”
Zorbalığı yapan çocuğun da en az maruz kalan çocuk kadar yardıma ihtiyacı olduğunu söyleyen Özkaya, "Sosyal becerilerini geliştirecek etkinliklere, spor ve sanat gibi alanlara yönlendirilmeli, gerektiğinde psikolojik destek almaları sağlanmalıdır. Zorbalığı yapan çocuğun da en az maruz kalan çocuk kadar yardıma ihtiyacı olduğu unutulmamalıdır. Özellikle sosyal medyada akran zorbalığına dair çok sayıda içerik karşımıza çıkmaktadır. Zorbalığın devam ettiğini anne ve baba bunu fark etmediği sürece çocuklar, kendilerine zarar verme, intihar etme, arkadaşlarına kötü davranma gibi ciddi sorunlarla karşı karşıya kalabilir. Bu nedenle anne babalar, çocuklarının sosyal medyada neler izlediğini ve nelere baktığını takip etmeyi bırakmamalı, onların güven içinde hayatlarına devam edebilmeleri için ellerinden geleni yapmalıdır. Özellikle 7-15 yaş arasındaki çocuklar akran zorbalığına maruz kaldığında ilerleyen yaşlarında depresyon, kaygı, özgüven problemleri gibi sıkıntılar yaşayabilir, hatta bunun daha ileri boyutu olan kendine zarar verme durumlarıyla karşılaşılabilir" şeklinde konuştu.